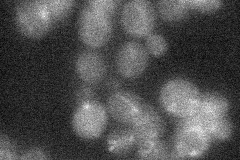

View description
ATP (CTP):tRNA-specific tRNA nucleotidyltransferase; different forms targeted to the nucleus, cytosol, and mitochondrion are generated via the use of multiple transcriptional and translational start sites
Localization:
Intensity:
Fold change:
Significance:
-
C’ GFP library in SD

cytosol40.24 -
N' NOP1pr-GFP in SD

mitochondria23.6516 -
N' TEF2pr-mCherry in SD

missing0 -
N' NATIVEpr-GFP in SD
below threshold17.7628 -
N' TEF2pr-VC and Cyto-VN in SD

#N/A0 -
C’ GFP library in SD+DTT

cytosol56.461.4Yes -
C’ GFP library in SD+H2O2

cytosol45.831.13No -
C’ GFP library in Starvation Media

cytosolN/AN/AYes -
C’ GFP library on the background of Pup2-DaMP

cytosol -
C’ GFP library on the background of CCT mutant

cytosol45.38931.12767No
